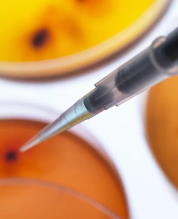
image.png

幹細胞多少錢
2024-10-14 15:23:02 來源: 小編 咨詢醫生
關于四川地區的幹細胞治療費用,需要明确的是,幹細胞技術在醫療領域的應用非常廣泛,從皮膚再生、抗衰老到疾病治療等多個方面都有所涉及。由于這項技術還處于相對早期的發展階段,并且涉及到複雜的醫學倫理和技術操作問題,因此在國内的普及程度和價格标準存在較大的地區差異和個人情況差異。
項目檢查費用:
-肺部CT掃描的費用大約在數百元至一千多元,具體的收費請向當地醫療機構或醫生咨詢以獲得确切的報價。
-超聲波檢查(B超)的費用通常在30元至500元範圍内。
-幹細胞治療的費用因治療目标的不同而異。鑒于幹細胞廣泛應用于多種疾病的治療和康複,其費用根據治療計劃、所需幹細胞類型及方案的不同,可能在數萬到數十萬人民币,甚至更高。
具體到四川,目前幹細胞療法主要應用于一些專業醫療機構或研究機構開展的臨床試驗項目中。
這類項目的收費通常由以下幾個部分構成:
1.初診咨詢費:患者初次前往醫院進行病情咨詢時可能需要支付一定的費用,這部分費用根據醫院等級及專家級别有所不同。
2.檢查評估費:爲了确保患者适合接受幹細胞治療,在正式開始前需要進行全面的身體檢查和評估,這部分費用會依據所需檢查項目而定。
3.幹細胞采集/培養費:如果使用自體幹細胞(即患者自身提取的幹細胞),則需支付相應的采集費用;如果是使用**的幹細胞,則還需考慮匹配篩選等環節産生的成本。
4.注射/移植手術費:将培養好的幹細胞注入患者體内是整個治療過程中的關鍵步驟之一,其費用也占比較大。
5.後期随訪觀察費:治療結束後,醫生會對患者進行一段時間的跟蹤觀察以評估療效并及時調整治療方案,這期間的門診複查等也會産生一定開銷。
上述各項費用加起來後,幹細胞治療的整體花費可能會比較高昂。但值得注意的是,不同類型的疾病、不同的治療方案以及患者個體差異等因素都會影響最終的收費标準。此外,由于國内對幹細胞療法的監管**還在不斷完善之中,市場上可能存在部分非正規機構擅自開展相關業務并随意定價的情況,因此建議廣大患者務必選擇具備合法資質的專業醫院進行咨詢和治療。
在考慮接受任何形式的幹細胞治療之前,請務必詳細了解相關信息,并與具有相應執業資格的醫生充分溝通,确保安全有效。國家衛生健康委員會等有關部門也在持續加強對幹細胞臨床研究和應用的規範管理,推動行業健康發展。
- 2024-09-05幹細胞植物移植費用大概多少
- 2024-10-26臨沂幹細胞移植費用大約是多少?是否有醫保?
- 2024-11-28幹細胞治療腸癌的費用貴不貴,具體花費有哪些
- 2024-11-10小孩出生幹細胞存儲費用收多少
- 2024-09-26細胞幹細胞移植費用及成功率分析
- 2024-10-22幹細胞移植用藥費用高嗎?如何降低費用?
- 2024-09-13幹細胞在抗衰老領域中的應用方向盤點
- 2024-09-18幹細胞認證機構有哪些,國内幹細胞權威機構排名
- 2024-09-20幹細胞美膚的療愈過程,幹細胞護膚真的好用嗎
- 2024-08-09廣州臍帶幹細胞存儲多少錢一年
- 2024-08-28多大年齡适合打幹細胞,幹細胞注射的最佳時期
- 2024-09-04幹細胞牙龈種植費用大概多少錢一顆
- 2024-07-18打幹細胞要打幾次才有效果,注射幹細胞的功效作用及次數介紹
- 2024-10-11山東青島哪裏可以捐贈幹細胞?有哪些正規機構推薦?
- 2024-09-22幹細胞療法騙局曝光,幹細胞療法可靠嗎
- 2024-09-11臍帶造血幹細胞存儲條件和方法
- 2024-09-09打幹細胞的作用和功效能管幾年,多少錢一針
- 2024-08-27幹細胞除皺費用,影響費用的因素有哪些
